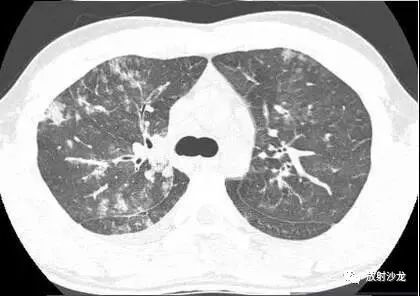
【病例】肺炎支原体肺炎1例CT影像表现
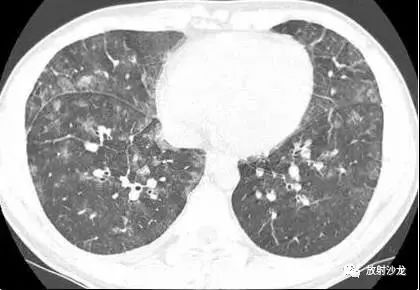
【病例】肺炎支原体肺炎1例CT影像表现

肺炎支原体肺炎1例CT影像表现
发布时间:2022-10-23
发布时间:2022-10-23
一名21岁男因发热咳嗽一周就诊。影像学结果检查如下:

图1
图2
图3

图4
胸部CT(图1-3)显示,支气管壁增厚,小叶中央型结节,磨玻璃影或小叶实变,轴向间质和小叶间隔增厚,以及双侧少量胸腔积液。胸片(图4)显示弥漫性斑片状或结节状磨玻璃影,线性阴影,以及双侧少量胸腔积液。
最终诊断:肺炎支原体肺炎
肺炎支原体肺炎是社区获得性肺炎的一种常见病因。肺炎支原体感染好发于儿童和年轻的成人;但是,约25%以上的肺炎支原体感染患者超过40岁。该病原体的靶点是呼吸道的纤毛细胞,其特点是急性细胞性细支气管炎伴水肿,支气管壁的溃疡性病变,支气管和血管周围的间质性病变,包含淋巴细胞,浆细胞和巨噬细胞。累及毛细支气管的肺泡周围包含单核细胞浸润。组织学上,典型的急性细胞毛细支气管炎可能进展为支气管肺炎。
X线片上最常见的表现是高密度影,节段性或非节段性分布。CT上,最常见的是支气管壁增厚(81%),其次是小叶中央型结节(78%),磨玻璃影(78%)和小叶实变(61%)。轴向间质及小叶间隔增厚常见。胸片中通常很难鉴别肺炎,但在高分辨CT中可见。其它表现是胸腔积液和淋巴结肿大。成人CT中常表现为细菌性支气管肺炎和病毒性间质性肺炎的合并感染。但儿童肺炎支原体肺炎与细菌性大叶性肺炎相似。